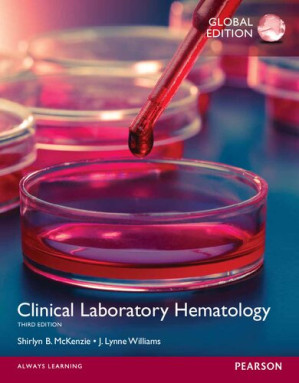

Clinical Laboratory Hematology Global Edition (Pearson Clinical Laboratory Science Series) – Shirlyn B. McKenzie, Lynne Williams
$17.99
EBOOK (PDF/EPUB)
High-quality searchable PDF format
No expiration. Unlimited downloads & online reading — yours to keep, forever
Works on all devices — PC, Mac, tablet & mobile. No special software needed
Description
ISBN-13: 9780133076011
Publisher: Pearson
Author: –
Language: English